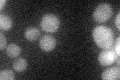
YPR185W
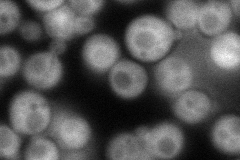
YPR185W
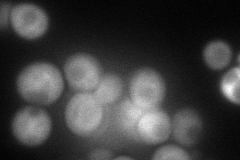
YPR185W
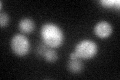
YPR185W
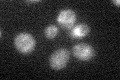
YPR185W

View description
Regulatory subunit of the Atg1p signaling complex; stimulates Atg1p kinase activity; required for vesicle formation during autophagy and the cytoplasm-to-vacuole targeting (Cvt) pathway; involved in Atg9p, Atg23p, and Atg27p cycling
Localization:
Intensity:
Fold change:
Significance:
-
C’ GFP library in SD
cytosol21.65 -
N' NOP1pr-GFP in SD
cytosol85.8424 -
N' TEF2pr-mCherry in SD
cytosol83.4361 -
N' NATIVEpr-GFP in SD

below threshold21.0267 -
N' TEF2pr-VC and Cyto-VN in SD

cytosol44.7854 -
C’ GFP library in SD+DTT
cytosol25.531.17No -
C’ GFP library in SD+H2O2

cytosol24.371.12No -
C’ GFP library in Starvation Media
cytosol24.931.15No -
C’ GFP library on the background of Pup2-DaMP

cytosol -
C’ GFP library on the background of CCT mutant

cytosol22.96571.06073No
